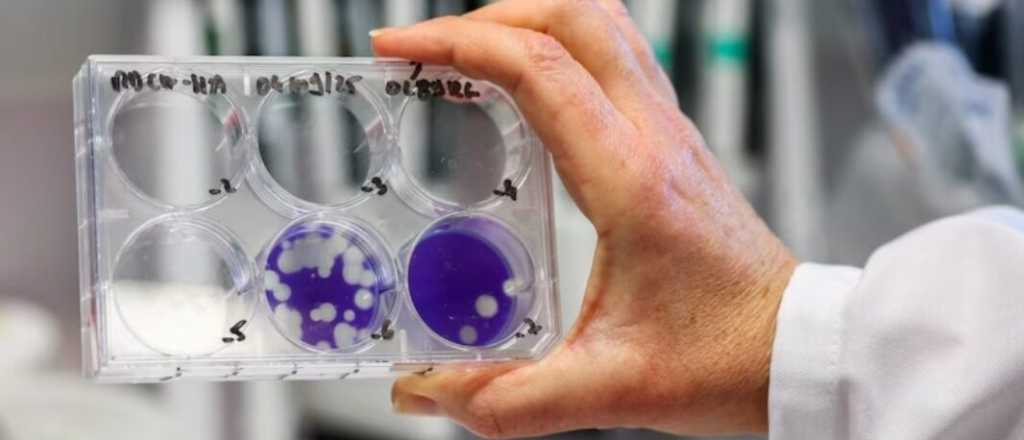
Confirmaron que el caso detectado en Mendoza es de "gripe K"

El Ministerio de Salud confirmó que el caso detectado en Mendoza corresponde a la variante K de la gripe A H3N2. Se trata de un paciente que llegó desde Europa y permanece internado.
Confirmaron que el caso detectado en Mendoza es de "gripe K"
Mendoza confirmó que el caso de gripe detectado días atrás corresponde a la variante K de la influenza A H3N2, una cepa que actualmente predomina durante el invierno del hemisferio norte y que se caracteriza por una mayor capacidad de transmisión.
La confirmación fue realizada por el Departamento de Epidemiología del Ministerio de Salud, luego de la revisión de los estudios realizada por el Instituto Malbrán, y marca la primera notificación oficial de esta variante en territorio mendocino.
El paciente es un turista español de 74 años, que llegó a la provincia para pasar las fiestas de fin de año y que comenzó a presentar síntomas respiratorios a los pocos días. Tras una primera atención en el Hospital Central, fue derivado al Hospital Carrillo, donde permanece internado en terapia intensiva.
Según se informó, el hombre presenta comorbilidades previas, entre ellas EPOC, cáncer de próstata y artritis, condiciones que influyeron en la gravedad de su cuadro clínico y motivaron un seguimiento médico estrecho.
El paciente permanece internado en el Hospital Carrillo.
El caso había sido comunicado inicialmente este miércoles 31 de diciembre como gripe A H3N2, pero recién en las últimas horas se confirmó que corresponde al subclado K, una mutación ya conocida del virus.
Ver: Mendocinos alertan sobre un "modus operandi" de robos camino a Chile
Con este diagnóstico, ya son seis los casos confirmados de la variante K en Argentina, con antecedentes en Santa Cruz, Buenos Aires, Neuquén y ahora Mendoza.
La variante K predomina en el hemisferio norte. En Argentina ya son seis los casos confirmados.
En materia de prevención, desde la cartera sanitaria y organismos internacionales como la OPS recordaron que la vacuna antigripal sigue siendo efectiva para reducir complicaciones y hospitalizaciones. Además, recomendaron reforzar la vacunación en grupos de riesgo y mantener medidas básicas de cuidado, como la ventilación de ambientes, el lavado frecuente de manos y la consulta médica ante síntomas respiratorios.
Leer: Las compras en Shein y Temu empujaron las importaciones en Argentina